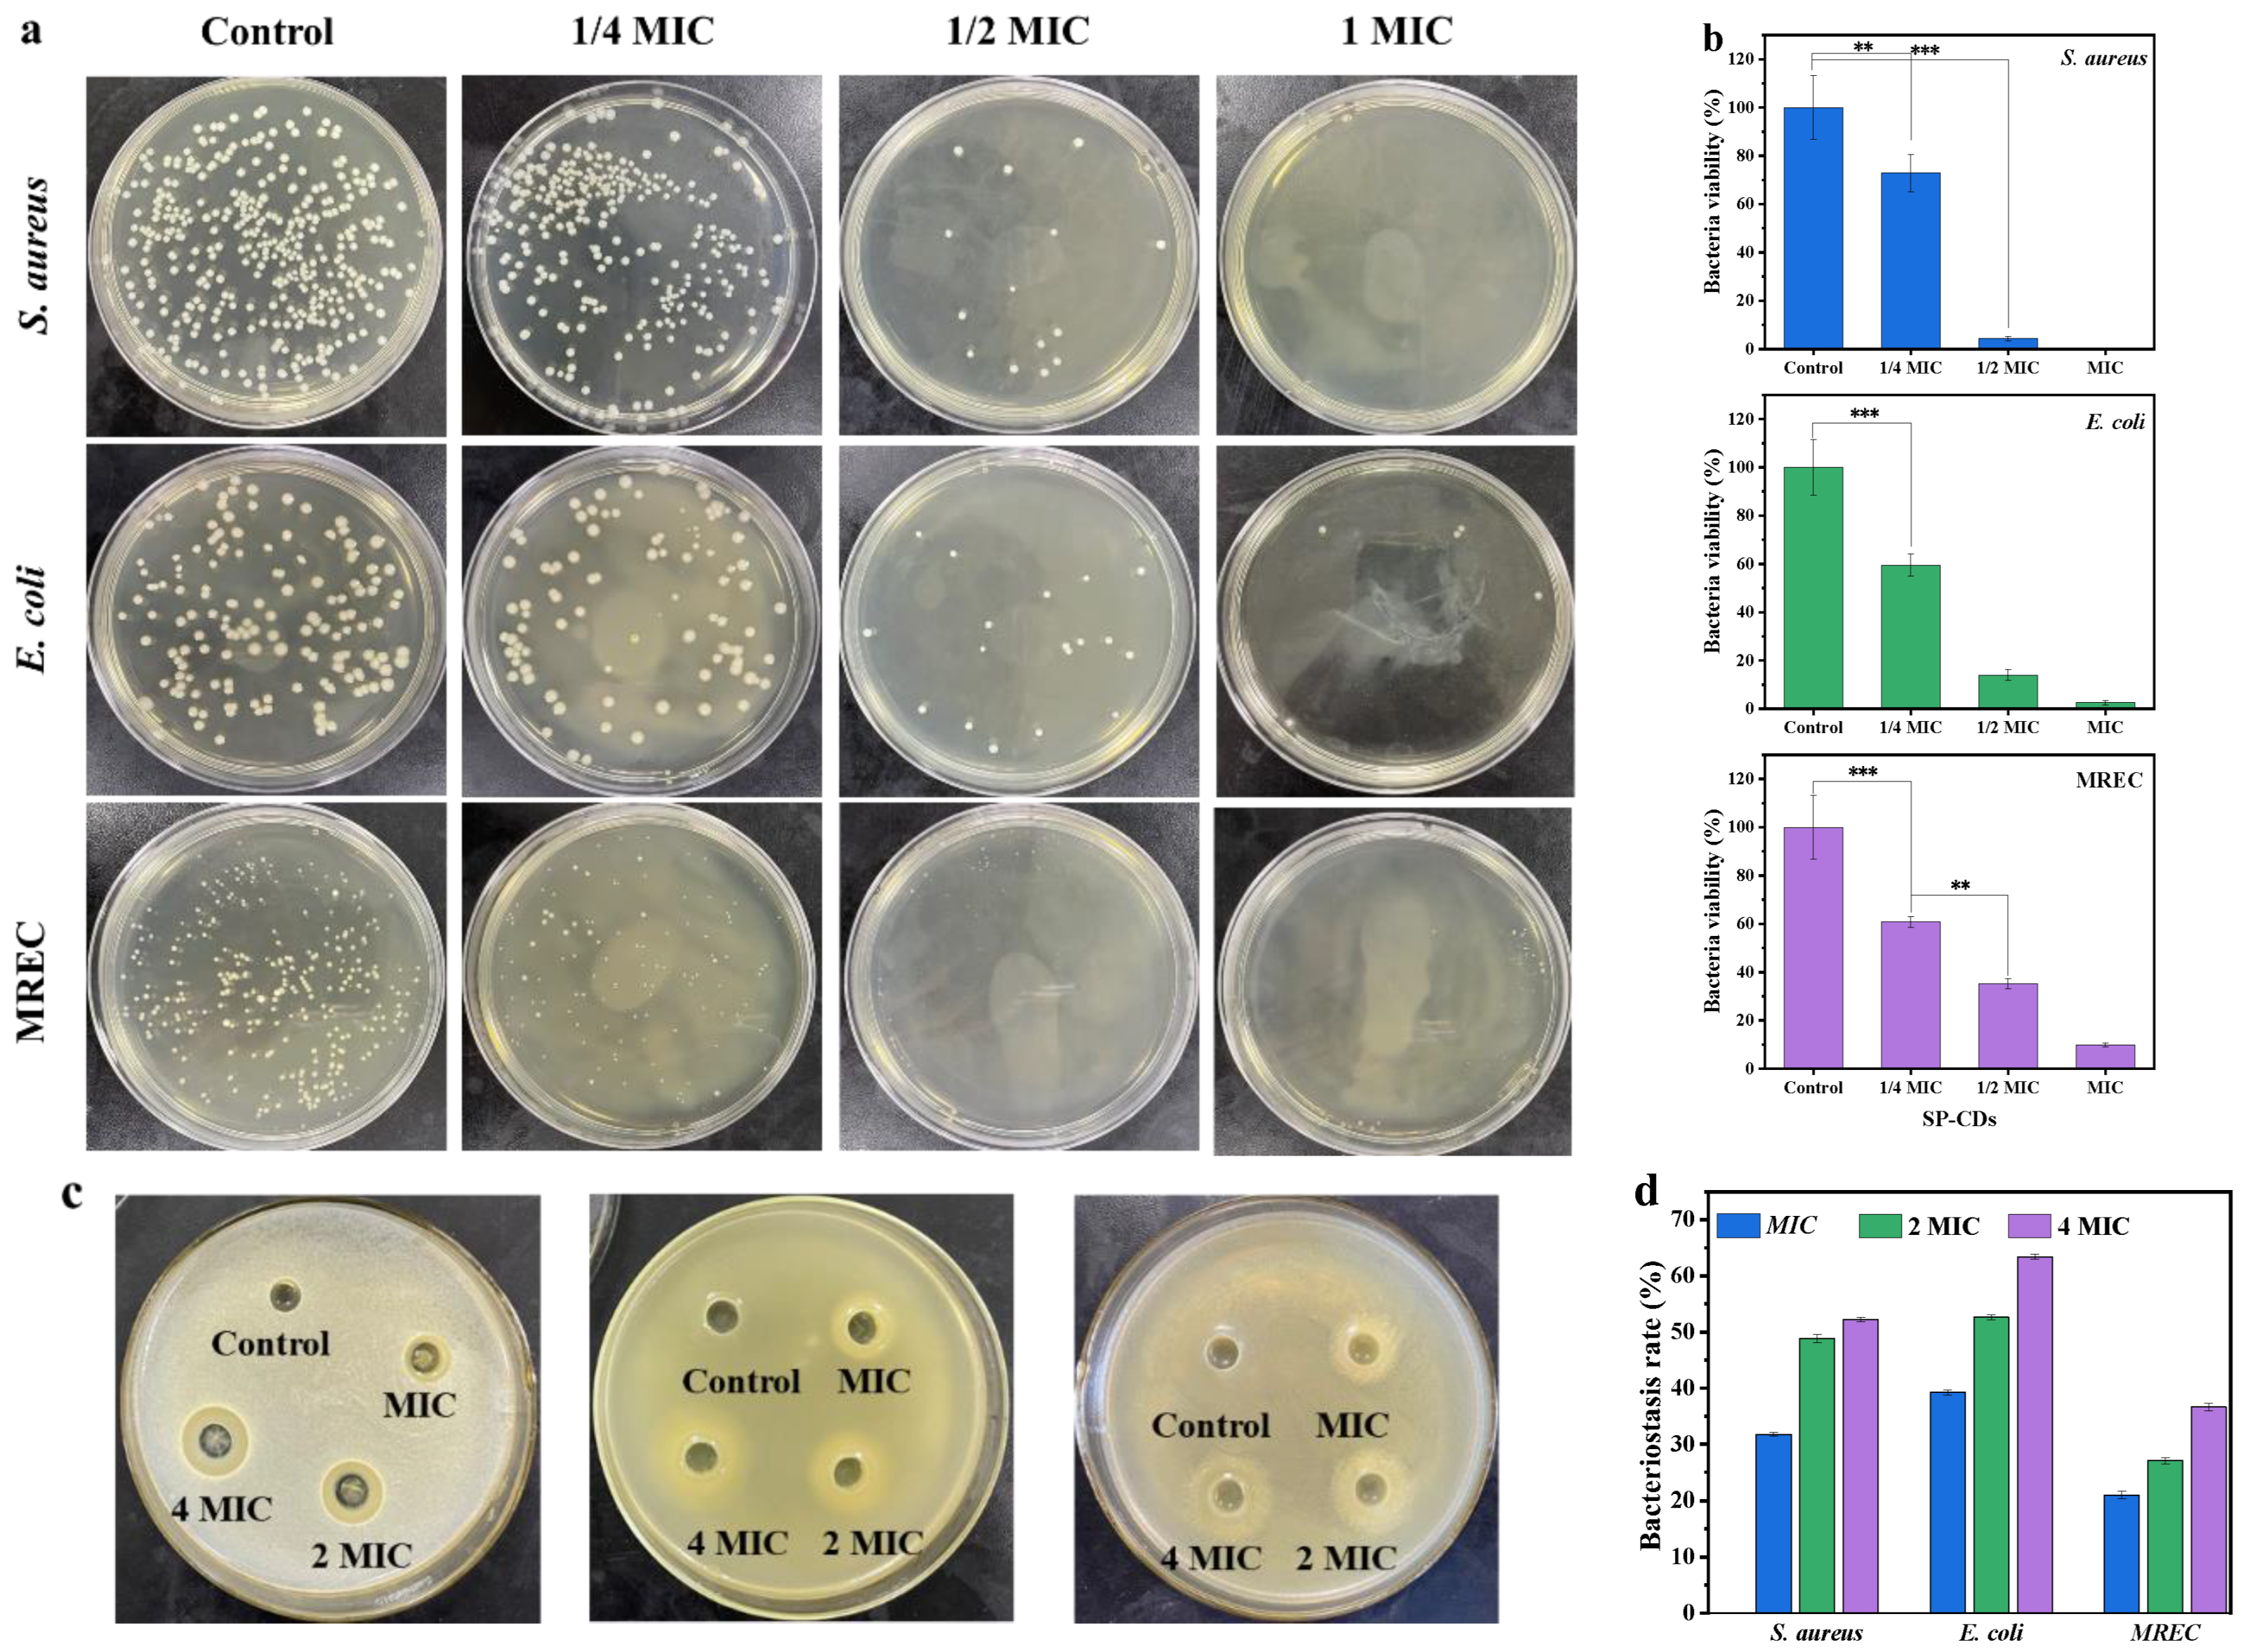
Foods 13 00058 g002

Synthesizing Carbon Quantum Dots via Hydrothermal Reaction to Produce Efficient Antibacterial and Antibiofilm Nanomaterials
Abstract
:1. Introduction
2. Materials and Methods
2.1. Materials
2.2. Strain and Bacteria Culture
2.3. Synthesis of SP-CDs
2.4. Characterization of SP-CDs
2.5. In Vitro Antibacterial Activity of SP-CDs
2.5.1. Minimum Inhibitory Concentration (MIC)
2.5.2. Determination of Bacteriostatic Circle
2.5.3. Flat Coating Method
2.6. Antibacterial Mechanism of SP-CDs
2.6.1. Bacterial Surface Charge Measurement
2.6.2. FT-IR Analysis of Bacterial
2.6.3. Confocal Laser Scanning Microscope (CLSM) Observation
2.6.4. Scanning Electron Microscope (SEM) Observation
2.6.5. Transmission Electron Microscope (TEM) Observation
2.6.6. Relative Amount of Extracellular Nucleic Acids of Bacteria
2.6.7. Relative Number of Extracellular Proteins of Bacteria
2.7. Antibiofilm Activity
2.8. Microbial Resistance Assay
2.9. Statistical Analysis
3. Results and Discussion
3.1. Performance Characterization of SP-CDs
3.1.1. Optical Properties of SP-CDs
3.1.2. Microstructure of SP-CDs
3.1.3. Chemical Composition of SP-CDs
3.2. Antibacterial Activity of SP-CDs
3.3. Antibacterial Mechanism of SP-CDs
3.3.1. Neutralization of Bacterial Surface Charge
3.3.2. FTIR Spectra of Bacterial Cells
3.3.3. TEM and SEM Used to Observe Morphological Changes
3.3.4. Leak of Cell Contents
3.3.5. CLSM Used to Observe Membrane Permeability
3.4. Antibacterial Mechanism of SP-CDs
3.5. Antibiofilm Activity of SP-CDs
3.6. Resistance Development of SP-CDs
4. Conclusions
Author Contributions
Funding
Institutional Review Board Statement
Informed Consent Statement
Data Availability Statement
Acknowledgments
Conflicts of Interest
References
- Tseng, Y.-C.; Xue, C.; Ng, I.S. Symbiosis culture of probiotic Escherichia coli Nissle 1917 and Lactobacillus rhamnosus GG using lactate utilization protein YkgG. Process Biochem. 2023, 126, 163–170. [Google Scholar] [CrossRef]
- Wu, S.; Zhang, Q.; Cong, G.; Xiao, Y.; Shen, Y.; Zhang, S.; Zhao, W.; Shi, S. Probiotic Escherichia coli Nissle 1917 protect chicks from damage caused by Salmonella enterica serovar Enteritidis colonization. Anim. Nutr. 2023, 14, 450–460. [Google Scholar] [CrossRef] [PubMed]
- Lin, Y.; Wang, R.; Li, X.; Addo, K.A.; Fang, M.; Zhang, Y.; Yu, Y. Antibacterial mechanism of kojic acid and tea polyphenols against Escherichia coli O157:H7 through transcriptomic analysis. Food Sci. Hum. Wellness 2024, 13, 736–747. [Google Scholar] [CrossRef]
- Choo, K.W.; Mao, L.; Mustapha, A. CAM-21, a novel lytic phage with high specificity towards Escherichia coli O157:H7 in food products. Int. J. Food Microbiol. 2023, 386, 110026. [Google Scholar] [CrossRef] [PubMed]
- Wang, L.; Liu, L.; Liu, Y.; Wang, F.; Zhou, X. Antimicrobial performance of novel glutathione-conjugated silver nanoclusters (GSH@AgNCs) against Escherichia coli and Staphylococcus aureus by membrane-damage and biofilm-inhibition mechanisms. Food Res. Int. 2022, 160, 111680. [Google Scholar] [CrossRef] [PubMed]
- Argudín, M.Á.; Mendoza, M.C.; Rodicio, M.R. Food poisoning and Staphylococcus aureus enterotoxins. Toxins 2010, 2, 1751–1773. [Google Scholar] [CrossRef] [PubMed]
- Kumari, N.; Kumar, S.; Karmacharya, M.; Dubbu, S.; Lee, I.S. Surface-textured mixed-metal-oxide nanocrystals as efficient catalysts for ROS production and biofilm eradication. Nano Lett. 2020, 21, 279–287. [Google Scholar] [CrossRef] [PubMed]
- Fan, X.; Yang, F.; Nie, C.; Ma, L.; Cheng, C.; Haag, R. Biocatalytic nanomaterials: A new pathway for bacterial disinfection. Adv. Mater. 2021, 33, e2100637. [Google Scholar] [CrossRef]
- Chen, Z.; Ji, H.; Liu, C.; Bing, W.; Wang, Z.; Qu, X. A Multinuclear Metal Complex Based DNase-Mimetic Artificial Enzyme: Matrix Cleavage for Combating Bacterial Biofilms. Angew. Chem. 2016, 55, 10732–10736. [Google Scholar] [CrossRef]
- Jian, H.J.; Wu, R.S.; Lin, T.Y.; Li, Y.J.; Lin, H.J.; Harroun, S.G.; Lai, J.Y.; Huang, C.C. Super-Cationic Carbon Quantum Dots Synthesized from Spermidine as an Eye Drop Formulation for Topical Treatment of Bacterial Keratitis. ACS Nano 2017, 11, 6703–6716. [Google Scholar] [CrossRef]
- Ananth, A.; Dharaneedharan, S.; Heo, M.-S.; Mok, Y.S. Copper oxide nanomaterials: Synthesis, characterization and structure-specific antibacterial performance. Chem. Eng. J. 2015, 262, 179–188. [Google Scholar] [CrossRef]
- Muthukumar, H.; Chandrasekaran, N.I.; Naina Mohammed, S.; Pichiah, S.; Manickam, M. Iron oxide nano-material: Physicochemical traits and in vitro antibacterial propensity against multidrug resistant bacteria. J. Ind. Eng. Chem. 2017, 45, 121–130. [Google Scholar] [CrossRef]
- Zheng, K.; Setyawati, M.I.; Leong, D.T.; Xie, J. Overcoming bacterial physical defenses with molecule-like ultrasmall antimicrobial gold nanoclusters. Bioact. Mater. 2021, 6, 941–950. [Google Scholar] [CrossRef] [PubMed]
- Maas, M. Carbon Nanomaterials as Antibacterial Colloids. Materials 2016, 9, 617. [Google Scholar] [CrossRef] [PubMed]
- Pan, T.; Chen, H.; Gao, X.; Wu, Z.; Ye, Y.; Shen, Y. Engineering efficient artificial nanozyme based on chitosan grafted Fe-doped-carbon dots for bacteria biofilm eradication. J. Hazard. Mater. 2022, 435, 128996. [Google Scholar] [CrossRef] [PubMed]
- Wang, M.; Kang, X.; Deng, L.; Wang, M.; Xia, Z.; Gao, D. Deep eutectic solvent assisted synthesis of carbon dots using Sophora flavescens Aiton modified with polyethyleneimine: Application in myricetin sensing and cell imaging. Food Chem. 2021, 345, 128817. [Google Scholar] [CrossRef]
- Demirci, S.; McNally, A.B.; Ayyala, R.S.; Lawson, L.B.; Sahiner, N. Synthesis and characterization of nitrogen-doped carbon dots as fluorescent nanoprobes with antimicrobial properties and skin permeability. J. Drug Deliv. Sci. Technol. 2020, 59, 101889. [Google Scholar] [CrossRef]
- Igarashi, K.; Kashiwagi, K. Modulation of cellular function by polyamines. Int. J. Biochem. Cell Biol. 2010, 42, 39–51. [Google Scholar] [CrossRef]
- Kwon, D.H.; Lu, C.D. Polyamine Effects on Antibiotic Susceptibility in Bacteria. Antimicrob. Agents Chemother. 2007, 51, 2070. [Google Scholar] [CrossRef]
- Li, Y.J.; Harroun, S.G.; Su, Y.C.; Huang, C.F.; Unnikrishnan, B.; Lin, H.J.; Lin, C.H.; Huang, C.C. Synthesis of Self-Assembled Spermidine-Carbon Quantum Dots Effective against Multidrug-Resistant Bacteria. Adv. Healthc. Mater. 2016, 5, 2545–2554. [Google Scholar] [CrossRef]
- Cui, F.; Sun, J.; Ji, J.; Yang, X.; Wei, K.; Xu, H.; Gu, Q.; Zhang, Y.; Sun, X. Carbon dots-releasing hydrogels with antibacterial activity, high biocompatibility, and fluorescence performance as candidate materials for wound healing. J. Hazard. Mater. 2021, 406, 124330. [Google Scholar] [CrossRef] [PubMed]
- Joshi, S.C.; Verma, A.R.; Mathela, C.S. Antioxidant and antibacterial activities of the leaf essential oils of Himalayan Lauraceae species. Food Chem. Toxicol. Int. J. Publ. Br. Ind. Biol. Res. Assoc. 2010, 48, 37–40. [Google Scholar] [CrossRef] [PubMed]
- Cui, T.; Bai, F.; Sun, M.; Lv, X.; Li, X.; Zhang, D.; Du, H. Lactobacillus crustorum ZHG 2-1 as novel quorum-quenching bacteria reducing virulence factors and biofilms formation of Pseudomonas aeruginosa. Lwt 2020, 117, 108696. [Google Scholar] [CrossRef]
- Jia, H.; Zeng, X.; Cai, R.; Wang, Z.; Yuan, Y.; Yue, T. One-pot synthesis of magnetic self-assembled carrageenan-epsilon-polylysine composites: A reusable and effective antibacterial agent against Alicyclobacillus acidoterrestris. Food Chem. 2021, 360, 130062. [Google Scholar] [CrossRef] [PubMed]
- Ramalingam, B.; Parandhaman, T.; Das, S.K. Antibacterial Effects of Biosynthesized Silver Nanoparticles on Surface Ultrastructure and Nanomechanical Properties of Gram-Negative Bacteria viz. Escherichia coli and Pseudomonas aeruginosa. ACS Appl. Mater. Interfaces 2016, 8, 4963–4976. [Google Scholar] [CrossRef] [PubMed]
- Wang, X.; He, S.; Yuan, L.; Deng, H.; Zhang, Z. Synthesis, Structure Characterization, and Antioxidant and Antibacterial Activity Study of Iso-orientin-Zinc Complex. J. Agric. Food Chem. 2021, 69, 3952–3964. [Google Scholar] [CrossRef]
- Damiano, S.; Forino, M.; De, A.; Vitali, L.A.; Lupidi, G.; Taglialatela-Scafati, O. Antioxidant and antibiofilm activities of secondary metabolites from Ziziphus jujuba leaves used for infusion preparation. Food Chem. 2017, 230, 24–29. [Google Scholar] [CrossRef]
- Lin, W.T.; Zhang, Y.Y.; Tan, H.L.; Ao, H.Y.; Duan, Z.L.; He, G.; Tang, T.T. Inhibited Bacterial Adhesion and Biofilm Formation on Quaternized Chitosan-Loaded Titania Nanotubes with Various Diameters. Materials 2016, 9, 155. [Google Scholar] [CrossRef]
- Huang, J.; Liu, Y.; Yang, L.; Zhou, F. Synthesis of sulfonated chitosan and its antibiofilm formation activity against E. coli and S. aureus. Int. J. Biol. Macromol. 2019, 129, 980–988. [Google Scholar] [CrossRef]
- Yang, H.; Jin, L.; Zhao, D.; Lian, Z.; Appu, M.; Huang, J.; Zhang, Z. Antibacterial and Antibiofilm Formation Activities of Pyridinium-Based Cationic Pillar[5]arene Against Pseudomonas aeruginosa. J. Agric. Food Chem. 2021, 69, 4276–4283. [Google Scholar] [CrossRef]
- Yang, P.; Zhu, Z.; Zhang, T.; Zhang, W.; Chen, W.; Cao, Y.; Chen, M.; Zhou, X. Orange-Emissive Carbon Quantum Dots: Toward Application in Wound pH Monitoring Based on Colorimetric and Fluorescent Changing. Small 2019, 15, e1902823. [Google Scholar] [CrossRef] [PubMed]
- Liu, X.; Liu, J.; Zheng, B.; Lei, Y.; Dan, X. N-Doped carbon dots: Green and efficient synthesis on a large-scale and their application in fluorescent pH sensing. New J. Chem. 2017, 41, 10607–10612. [Google Scholar] [CrossRef]
- Xu, X.; Bao, Z.; Zhou, G.; Zeng, H.; Hu, J. Enriching Photoelectrons via Three Transition Channels in Amino-Conjugated Carbon Quantum Dots to Boost Photocatalytic Hydrogen Generation. ACS Appl. Mater. Interfaces 2016, 8, 14118–14124. [Google Scholar] [CrossRef] [PubMed]
- Zhan, Y.; Shang, B.; Chen, M.; Wu, L. One-Step Synthesis of Silica-Coated Carbon Dots with Controllable Solid-State Fluorescence for White Light-Emitting Diodes. Small 2019, 15, e1901161. [Google Scholar] [CrossRef] [PubMed]
- Cui, Y.; Zhang, J.; Zhang, G.; Huang, J.; Liu, P.; Antonietti, M.; Wang, X. Synthesis of bulk and nanoporous carbon nitride polymers from ammonium thiocyanate for photocatalytic hydrogen evolution. J. Mater. Chem. 2011, 21, 13032. [Google Scholar] [CrossRef]
- Yang, S.; Gong, Y.; Zhang, J.; Zhan, L.; Ma, L.; Fang, Z.; Vajtai, R.; Wang, X.; Ajayan, P.M. Exfoliated graphitic carbon nitride nanosheets as efficient catalysts for hydrogen evolution under visible light. Adv. Mater. 2013, 25, 2452–2456. [Google Scholar] [CrossRef] [PubMed]
- Li, W.; Wu, S.; Zhang, H.; Zhang, X.; Zhuang, J.; Hu, C.; Liu, Y.; Lei, B.; Ma, L.; Wang, X. Enhanced Biological Photosynthetic Efficiency Using Light-Harvesting Engineering with Dual-Emissive Carbon Dots. Adv. Funct. Mater. 2018, 28, 1804004. [Google Scholar] [CrossRef]
- Liu, Y.; Guo, Z.; Li, F.; Xiao, Y.; Zhang, Y.; Bu, T.; Jia, P.; Zhe, T.; Wang, L. Multifunctional Magnetic Copper Ferrite Nanoparticles as Fenton-like Reaction and Near-Infrared Photothermal Agents for Synergetic Antibacterial Therapy. ACS Appl. Mater. Interfaces 2019, 11, 31649–31660. [Google Scholar] [CrossRef]
- Zheng, K.; Setyawati, M.I.; Leong, D.T.; Xie, J. Antimicrobial silver nanomaterials. Coord. Chem. Rev. 2018, 357, 1–17. [Google Scholar] [CrossRef]
- Shang, L.; Nienhaus, K.; Nienhaus, G.U. Engineered Nanoparticles Interacting with Cells: Size Matters. J. Nanobiotechnology 2014, 12, 5. [Google Scholar] [CrossRef]
- Morones, J.R.; Elechiguerra, J.L.; Camacho, A.; Holt, K.; Kouri, J.B.; Ramírez, J.T.; Yacaman, M.J. The bactericidal effect of silver nanoparticles. Nanotechnology 2005, 16, 2346–2353. [Google Scholar] [CrossRef] [PubMed]

Disclaimer/Publisher’s Note: The statements, opinions and data contained in all publications are solely those of the individual author(s) and contributor(s) and not of MDPI and/or the editor(s). MDPI and/or the editor(s) disclaim responsibility for any injury to people or property resulting from any ideas, methods, instructions or products referred to in the content. |
© 2023 by the authors. Licensee MDPI, Basel, Switzerland. This article is an open access article distributed under the terms and conditions of the Creative Commons Attribution (CC BY) license (https://creativecommons.org/licenses/by/4.0/).
Share and Cite
Cui, T.; Fan, Y.; Liu, Y.; Ding, Y.; Li, X.; Cheng, G.; Cheng, J. Synthesizing Carbon Quantum Dots via Hydrothermal Reaction to Produce Efficient Antibacterial and Antibiofilm Nanomaterials. Foods 2024, 13, 58. https://doi.org/10.3390/foods13010058
Cui T, Fan Y, Liu Y, Ding Y, Li X, Cheng G, Cheng J. Synthesizing Carbon Quantum Dots via Hydrothermal Reaction to Produce Efficient Antibacterial and Antibiofilm Nanomaterials. Foods. 2024; 13(1):58. https://doi.org/10.3390/foods13010058
Chicago/Turabian StyleCui, Tianqi, Ya Fan, Yaping Liu, Yangyue Ding, Xinyue Li, Guiguang Cheng, and Jianjun Cheng. 2024. "Synthesizing Carbon Quantum Dots via Hydrothermal Reaction to Produce Efficient Antibacterial and Antibiofilm Nanomaterials" Foods 13, no. 1: 58. https://doi.org/10.3390/foods13010058
APA StyleCui, T., Fan, Y., Liu, Y., Ding, Y., Li, X., Cheng, G., & Cheng, J. (2024). Synthesizing Carbon Quantum Dots via Hydrothermal Reaction to Produce Efficient Antibacterial and Antibiofilm Nanomaterials. Foods, 13(1), 58. https://doi.org/10.3390/foods13010058







